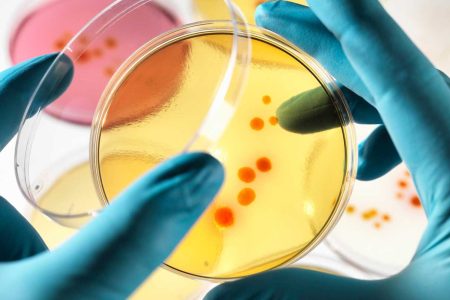
Cancer Cure Could Lead to Bioweapons

Trump’s Effort to Stop North Korea Could Keep $80 Million from Scaramucci
The sale of Scaramucci's firm would be halted if Trump blocks Chinese deals.
NASA Is Hiring Someone to Defend Earth from Aliens
The planetary protection officer will get paid six figures.
The World’s Longest Pedestrian Suspension Bridge Opens in Switzerland
The 1,621-foot-long bridge hangs nearly 300 feet above the valley floor in the Swiss Alps.
Why the Space Junk Problem Is Going to Get A Lot Worse
Low-Earth orbit is already filled with millions of pieces of debris.
Custom Cancer Cures Could Lead to DNA-Specific Bioweapons
Intel's chief medical officer is worried about widespread human genome hacks.
White House Staffers Duped by ‘Email Prankster’ Posing as Kushner, Preibus
Anthony Scaramucci and Tom Bossert were among many in the White House targeted.
Why Wall Street Fears Jeff Bezos More Than Donald Trump or Vladimir Putin
Executives increasingly feel threatened by the ever-expanding Amazon empire.
Medical Implants to Fight Pain Could Solve America’s Opioid Addiction
Neurostimulation devices are a non-addictive alternative for pain treatment.
Honolulu Will Fine People for Texting and Walking Starting in October
New law forbids pedestrians for using their phone on the go in the Hawaiian city.
EPA Museum Being Adjusted to Reflect Trump Administration’s Priorities
The history of the EPA will look a little different once the updates are made.
Uber’s CEO Search Struggles Continue With Travis Kalanick Meddling
The list of candidates for the ride sharing company's CEO is reportedly all males.
How Tesla’s Model 3 Is the Final Step in Elon Musk’s Master Plan
Debut of new, mass-market Tesla is the culmination of a decade-long strategy.
Are You Prepared For the Coming App Apocalypse?
Rollout of Apple's new iOS11 this September will result in a purge of thousands of old apps.
Which U.S. States Curse the Most at Customer Service Representatives?
Frequency and strength of profanity in complaints to 500 top brands varies from state to state.
Netflix Launched a Cyberattack Against Itself to Help Save the Internet
Company found a potentially fatal flaw, took pre-emptive action to prevent widespread web outage.
Half of Everything in Our Galaxy Is Made of Atoms from Across the Universe
Exploding stars blew 50 percent of Milky Way atoms through space on 'solar winds.'